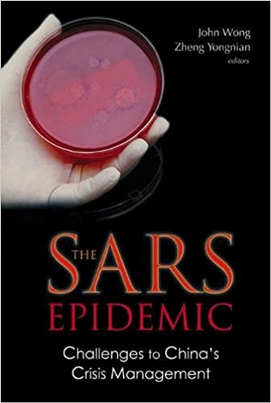
Image 4.png

This article is part of ourEconomy's 'Decolonising the economy' series.
To understand the socio-economic impacts of COVID-19, it is necessary to draw on insights from a broad range of disciplines and geographies. To this end, D-Econ has put together a list of readings to help you decolonize your reading list about the pandemic. Included in this list you’ll find research based on the West African experience with Ebola, China’s experience with SARS and Zimbabwe’s experience with Cholera, which is all relevant for understanding the present crisis. Furthermore, we’ve included books that unpack the racial inequalities underpinning the American health system, how the World Trade Organization as well as international financial institutions impact and interact with domestic health institutions, and how pandemics historically have shaped all aspects of society. You’ll also find books that present a feminist lens on understanding economies and useful background reading for understanding the risk of new debt crises in Africa.
Decolonizing Ebola Rhetorics Following the 2013-2016 West African Ebola Outbreak (2020)
By Marouf Hasian, Jr.

Decolonizing Ebola Rhetorics defends the position that despite the supposed ‘lessons’ that have been learned about the spread of Ebola Virus Disease (EVB) after the 2013-2016 West African Ebola Outbreak, there remains a need to ‘decolonize’ the rhetorics of Ebola prevention and containment. The author asserts that the failure of governments, aid organisations, and global media to confront the structural and material legacies of colonialism in West Africa will prevent global communities form adequately dealing with sporadic Ebola outbreaks.
Borders of an Epidemic: Covid 19 and Migrant Workers (2020)
Edited by Ranabir Samaddar

The sudden economic lockdown imposed by the Indian government as a measure to contain the spread of the pandemic resulted in an exodus of short-term informal migrant workers from Indian cities. The unplanned lockdown was a logistical nightmare, with millions of migrant workers finding themselves stranded with no means to get back home; many cycled and walked thousands of kilometres, while several succumbed to death. In this context, the book offers a wide range of in-depth and well-researched essays on the impact of the lockdown on migrant workers in India, how the impact has varied across social identities, such as caste and gender, how the government’s strategies to contain the spread operates differentially along the lines of these identities, and the implication of the pandemic on the global economic order. The rich and detailed narratives are placed in the context of broader (national as well as trans-national) structural factors, making this collection a rather timely and important read.
Just Medicine: A Cure for Racial Inequality in American Health Care (2013)
By Dayna Bowen Matthew

This is an important intervention in debates about the inadequacies of American health care, as it points to the massive health disparities along racial lines. This is essential to understand in the wake of COVID-19, where it is evident that minorities are disproportionately affected by the pandemic. Matthew demonstrates that health disparities in the United States have remained stubbornly entrenched in the health care system. She unpacks the role implicit biases play in exacerbating these inequalities, by combining insights from medical, neuroscience, psychology, sociology and legal research.
The SARS Epidemic: Challenges to China's Crisis Management (2004)
Edited by John Wong and Zheng Yongnian
This book examines the strengths and weaknesses of the political systems in China and Hong Kong in terms of how they managed the SARS crisis of 2003. In particular, the book explores the effectiveness of the two societies’ political and institutional mobilization, the capability of their respective bureaucracies, and the viability of their governance systems. The chapters in this book hold much relevance for contemporary discussions about how different institutional configurations have been able to cope with COVID-19 in different ways, and especially for discussion about how China itself dealt with COVID-19.
Trade Agreements and Public Health: A Primer for Health Policy Makers, Researchers and Advocates (2020)
By Deborah Gleeson and Ronald Labonté

This volume provides an introduction and important discussions of the implications of trade treaties for health services, access to medicines, unhealthy commodities, labour rights and the environment. Several chapters in the book are of particular relevance in the light of the current pandemic, as they unpack how the World Trade Organization constrains countries’ space to protect public and environmental health. The book also unpacks the policy-making process behind trade treaties and methods for trade and health research. In April 2020, Deborah Gleeson also wrote about the links between trade treaties and the Australian response to COVID-19 for The Conversation.
The Political Life of an Epidemic: Cholera, Crisis and Citizenship in Zimbabwe (2020)
By Simukai Chigudu

The Political Life of an Epidemic is a historical and political analysis of Zimbabwe’s catastrophic cholera outbreak in 2008/09, which was one of the worst in African history. Key to Chigudu's interpretation of the failure in containing the crisis is his emphasis on the country’s deepening inequality over the years. The collapse of public healthcare infrastructure, weak bureaucratic institutions and transnationalised disorder are some important considerations. The book is an important lesson in revealing how epidemics can be prevented and managed.
Social Reproduction Theory: Remapping Class, Recentering Oppression,
Edited by Tithi Bhattacharya

This edited book is a collection of some of the most significant interventions on Social Reproduction Theory in the last decade. Although not specifically about Covid-19 or epidemics, the theoretical contribution of the book forms an important basis to understand and analyse the impact of pandemic on the process of social reproduction (Here is an interview with the editor on the relation between SRT and Covid-19). Further, with the deepening of the structural fault lines in the economy due to the pandemic and an increasing momentum for structural reforms, several essays in the book offer important insights for a theoretically informed praxis.
Banking on Health: The World Bank and Health Sector Reform in Latin America (2017)
By Shiri Noy

This book provides a thorough case study approach to answer the question of why the World Bank was unable to effect sweeping neoliberal health reforms in Latin America. It argues that the reasons lie in the World Bank not having promoted a uniformly neoliberal, monolithic agenda in health and that countries’ autonomy and capacity in this sector shape how the World Bank is involved in reforms. The book also distinguishes neoliberal ends from means in health sector reform and traces changes in “banking on health” over time.
Africa's Odious Debts: How Foreign Loans and Capital Flight Bled A Continent (2011)
By Léonce Ndikumana and James K. Boyce

This now classic book on African debt demonstrates that, contrary to the popular perception of Africa being a drain on the financial resources of the West, the continent is actually a net creditor to the rest of the world. The book documents the intimate links between foreign loans and capital flight, and how debt-service payments continue to drain scarce resources from the continent, cutting into funds available for public health and other needs. This is an important background for understanding the underfinancing of health systems in many African countries, but also to understand the political economy of the contemporary debt and capital flight crises unfolding on the continent in the wake of the pandemic.
Epidemics and Society: From the Black Death to the Present (2019)
By Frank M. Snowden

This is a timely book which provides an interdisciplinary and comparative perspective on the medical and social history of major epidemics through time. Written in an accessible manner by historian Frank Snowden, the book looks specifically at how epidemic outbreaks have shaped societies, not simply in terms of medical science and public health, but also at how they transform the arts, religion, intellectual history and warfare. Since the outbreak of COVID-19, Snowden has demonstrated how the findings in his book can be applied to understand the current pandemic, for example on DemocracyNow! (video).
Everybody loves a good drought (1996)
By P. Sainath

While a relatively older collection of essays by Indian journalist P. Sainath, the book remains extremely relevant even today to analyse development projects at the grass-root level. Through this collection, Sainath shows that while there isn’t a marked change in lives of the subjects of these development projects, the entire development sector (NGOs, government machinery, and other institutions) thrives on and makes money out of these projects. Further, with media houses being owned by corporates, little to no space is provided to these issues in the media. The collection implicitly, and, at times, explicitly, indicates how poverty, underdevelopment, and economic misery is often lucrative for the institutions involved in its alleviation.